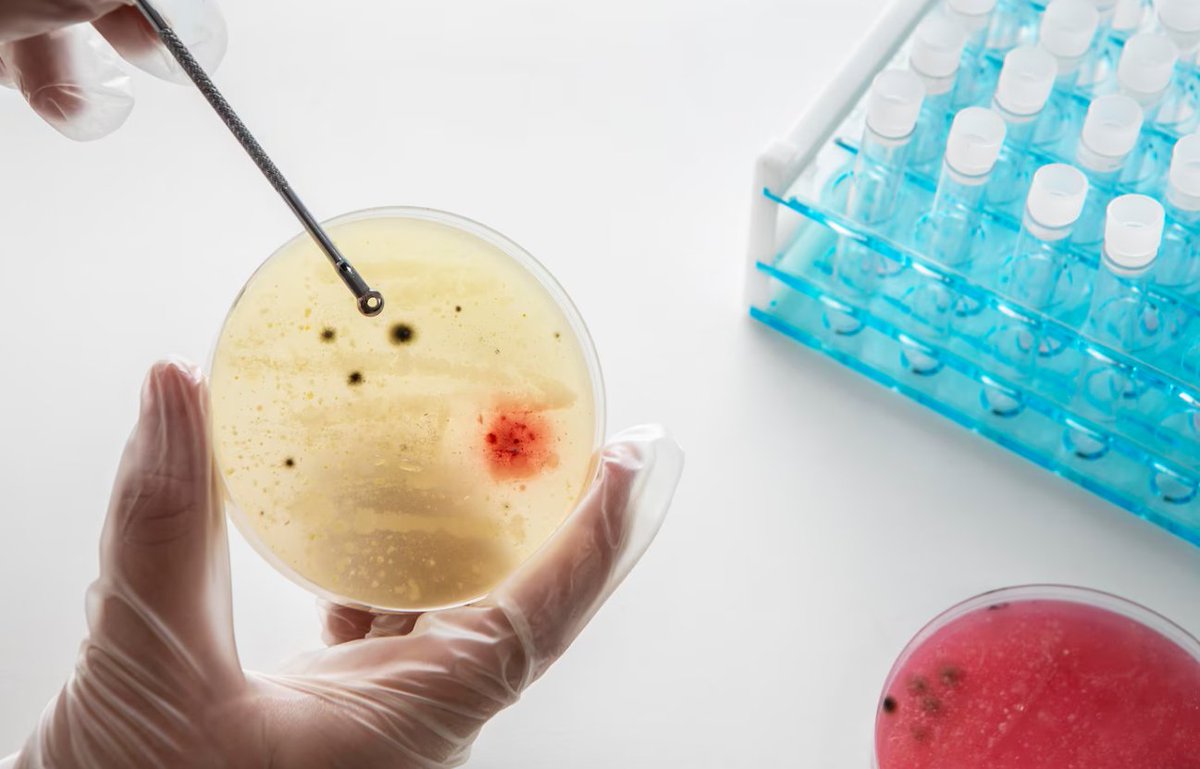
MediTechInsight's tweet image. 🔬 In Vitro Toxicity Testing Market to Surge ~10% CAGR by 2030: Innovation, Ethics &amp;amp; Efficiency Driving Growth

See report here: meditechinsights.com/in-vitro-toxic…

#InVitroTesting #Toxicology #CellCulture #InVitroToxicity #ToxicologyTesting #CellBasedAssays #DrugSafety #LabTesting

#invitrotesting resultados de búsqueda
We're still at In Cosmetics Global 2018! At this moment our colleague Irene Zaldívar Notario, Ph.D., MBA is teaching the technical seminar "Microbiome VS Skincare". One more year with great audience success!#ZurkoResearch #ClinicalEvaluation #InVitroTesting

Seguimos en In Cosmetics Global 2018! En estos momentos nuestra compañera Irene Zaldívar Notario, Ph.D., MBA está impartiendo el seminario técnico "Microbiome VS Skincare". Un año más con gran éxito de audiencia! #ZurkoResearch #ClinicalEvaluation #InVitroTesting

Emulate is a leading company for #invitrotesting, and this funding, led by investor Northpond Ventures with Perceptive Advisors, will enable researchers to replicate and study human biology, and understand drug response with greater precision and detail than animal testing.


Excited to be with our colleagues and peers at BIO International Convention. Who will we see here?#bio2017 #invitrotesting #hepatocytes

At XCellR8, we don't use any animals or animal-derived components in our lab. #animalfreetesting #invitrotesting #safetytesting

Meet Cytes Biotechnologies, SL R&D Director, Natalia Sánchez Romero, at #EUROTOX2019 Today, she is presenting our Poster: P06-101 "Primary human hepatocytes production for pharmacology, toxicology and basic research: four years experience" @EUROTOX_ #InVitroTesting

[Apprenticeship at HelioScreen Cosmetic Science] We are pleased to announce the arrival of our last recruit, Anaïs Tabariès, her mission is to create a biodegradability method to offer you a new test very soon ⚗🧪🧴 Welcome to our team, Anaïs! 💪 #invitrotesting #cosmetic
![centreWENEOS's tweet image. [Apprenticeship at HelioScreen Cosmetic Science]
We are pleased to announce the arrival of our last recruit, Anaïs Tabariès, her mission is to create a biodegradability method to offer you a new test very soon ⚗🧪🧴
Welcome to our team, Anaïs! 💪
#invitrotesting #cosmetic](https://pbs.twimg.com/media/FCnbc6WXsAQty1f.png)
Today is my first #anniversary at @UTSEngage in @UTSFEIT. Already so many good memories despite the many challenges and looking forward to many more to come in the future #Bioprinting #invitrotesting #3dcocultures #bioinks #beatingminihearts #heartresearch
[Apprenticeship at HelioScreen Cosmetic Science]☀️🧴 We are pleased to announce the arrival of our new recruit, Lisa, who will support the commercial and marketingdepartment.☀️ Welcome in our team Célia! ☀️🧴 #invitrotesting #invitro #cosmetic #science #infrared #sunprotection
![centreWENEOS's tweet image. [Apprenticeship at HelioScreen Cosmetic Science]☀️🧴
We are pleased to announce the arrival of our new recruit, Lisa, who will support the commercial and marketingdepartment.☀️
Welcome in our team Célia! ☀️🧴
#invitrotesting #invitro #cosmetic #science #infrared #sunprotection](https://pbs.twimg.com/media/FbjjnrvXoAIqgVk.jpg)
[Apprenticeship at HelioScreen Cosmetic Science]☀️🧴 We are pleased to announce the arrival of our new recruit, Célia, who will support the commercial department.☀️ Welcome in our team Célia! ☀️🧴 #invitrotesting #invitro #cosmetic #science #infrared #bluelight #sunprotection
![centreWENEOS's tweet image. [Apprenticeship at HelioScreen Cosmetic Science]☀️🧴
We are pleased to announce the arrival of our new recruit, Célia, who will support the commercial department.☀️
Welcome in our team Célia! ☀️🧴
#invitrotesting #invitro #cosmetic #science #infrared #bluelight #sunprotection](https://pbs.twimg.com/media/FbjidFrWIAEy2c0.jpg)
📷 So what actually is in vitro testing for cosmetics 📷 #invitrotesting #cosmeticstesting #animalfreetesting #nonanimaltesting #betterscience #theprocessofanimaltestinghasneverbeenscientificallyvalidated @CBUK10 @cbuk22 @ArtCBUK

Visit LifeNet Health LifeSciences expert scientists at #2021SOT Booth#1322. They are eager to share exciting developments around our expanding portfolio of high-quality, human-based research solutions. #invitrotesting #human3Dmodels #safetyassessment bit.ly/3bDiRgq

Visit LifeNet Health LifeSciences expert scientists at #2021SOT. They are eager to share exciting developments around our expanding portfolio of high-quality, human-based research solutions. #invitrotesting #human3Dmodels #safetyassessment bit.ly/3bDiRgq

One #2021SOT session focused on future animal-free tox testing & use of new alternative methodologies. LNH LifeSciences is developing multilayered & multicellular models to help in addressing this effort. #invitrotesting #human3Dmodels #safetyassessment bit.ly/3bDiRgq

In this paper, the teams from @Poietis and @BASF worked together to refine a 4D bioprinting protocol in which microvalve and laser-assisted printing techniques were used to produce skin equivalent tissue ... Read more here: scintica.com/products/ngb-r… #bioprinting #invitrotesting

Skin on a chip, thanks to microfluidics #skin #invitrotesting #Cosmeticstesting #Skinmodels #alternativetoanimaltesting lnkd.in/gQBcknQ
The market for #primarycellculture is expanding in part because primary cell cultures are being used for #invitrotesting and #medicationscreening. Read More: bit.ly/43LwUc3

We are attending #EUROTOX2019 held in Helsinki (Finland), from 8th to 11th September. Meet us in our poster presentation (P06-101) or contact us to schedule a meeting! More info: bit.ly/2lD7zB2 @EUROTOX_ #InVitroTesting

🔬 In Vitro Toxicity Testing Market to Surge ~10% CAGR by 2030: Innovation, Ethics & Efficiency Driving Growth See report here: meditechinsights.com/in-vitro-toxic… #InVitroTesting #Toxicology #CellCulture #InVitroToxicity #ToxicologyTesting #CellBasedAssays #DrugSafety #LabTesting

New publication by our research group! Let’s continue pushing for safer healthcare products. 🧤🧪 tandfonline.com/eprint/QEA3IS3… #Cytotoxicity #InVitroTesting #MedicalDevices #Toxicology #RegulatoryScience #HealthcareSafety #PPE #Gloves #COVID19 #L929 #NRU #Pharmacopoeia #ISO10993
tandfonline.com
A comparative analysis of in vitro cytotoxicity across various glove types using four different...
The coronavirus disease 2019 (COVID-19) pandemic has led to increased use of protective materials among healthcare workers and the general population, resulting in a rise in health issues such as a...
Innovations in in vitro testing are revolutionizing drug & medical device development. Faster, safer, more accurate results drive progress. cmdclabs.com/innovations-in… #InVitroTesting #MedicalInnovation #DrugDevelopment #NewYork #California #Florida
"Fast, accurate respiratory testing 🧫. The market for respiratory pathogen kits is growing with global demand for rapid diagnostics. 👉 medmarketdata.com/market-reports… #Diagnostics #RespiratoryHealth #InVitroTesting"
medmarketdata.com
$5.03 Billion Respiratory Pathogen Testing Kits Market to Revolutionize Diagnostics in the U.S.,...
Explore comprehensive insights into the respiratory pathogen testing kits market, including market predictions, technological advancements, and global trends.
🔬 In Vitro Toxicity Testing Market to Surge ~10% CAGR by 2030: Innovation, Ethics & Efficiency Driving Growth See report here: meditechinsights.com/in-vitro-toxic… #InVitroTesting #Toxicology #CellCulture #InVitroToxicity #ToxicologyTesting #CellBasedAssays #DrugSafety #LabTesting
Ensure product safety and effectiveness with in-vitro testing at CMDC Labs. Customized solutions, fast turnaround times, and proven compliance. cmdclabs.com/in-vitro-testi… #InVitroTesting #SkincareScience #CMDCLabs
cmdclabs.com
In Vitro Testing
Revolutionizing Skincare Science through In-Vitro Efficacy Testing! Protect Your Brand and Customers with Our Reliable Testing Solutions. Ready to Safeguard Your Products? At CMDC Labs We offer...
Take respiratory research further with Biochemazone's Artificial Mucoid Nasal Discharge! Ideal for in vitro studies, device testing, & nasal treatment development. Learn more: biochemazone.com/product/mucoid… #RespiratoryResearch #ArtificialFluids #InVitroTesting

Ensure your products deliver as promised! Our In-Vitro Efficacy Testing validates safety and performance under real-world conditions. Let science back your innovation: cmdclabs.com/in-vitro-testi… #InVitroTesting #LabServices #Innovation
cmdclabs.com
In Vitro Testing
Revolutionizing Skincare Science through In-Vitro Efficacy Testing! Protect Your Brand and Customers with Our Reliable Testing Solutions. Ready to Safeguard Your Products? At CMDC Labs We offer...
Ensure your products deliver as promised! Our In-Vitro Efficacy Testing validates safety and performance under real-world conditions. Let science back your innovation: cmdclabs.com/in-vitro-testi… #InVitroTesting #LabServices #Innovation
cmdclabs.com
In Vitro Testing
Revolutionizing Skincare Science through In-Vitro Efficacy Testing! Protect Your Brand and Customers with Our Reliable Testing Solutions. Ready to Safeguard Your Products? At CMDC Labs We offer...
At Chemzin Biotox Research Institute Pvt. Ltd., we excel in preclinical research using advanced in-vitro and in-vivo testing. Get Quote: chemzinbiotox.com/preclinical-re… #PreclinicalResearch #InVitroTesting #InVivoTesting #MedicalResearch #ChemzinBiotox #ResearchInstitute

🔬 Leveraging AI for #InVitroTesting: Using PubTator3 API, I'm extracting cell lines & gene names from OECD guidelines. AI-driven NER streamlines info extraction, advancing non-animal testing methods. Excited to explore more! #AI #Biotech #PubTator3 #OECD
Below, Junior Toxicologist Ben Arceneaux goes into detail about new approach methods in Toxicology— specifically, that of in vitro testing for chemical safety. 🧪 Learn More: hubs.la/Q02x-V0b0 - #InVitroTesting #Toxicology #NewApproachMethods #NAMs

Embracing the Future: How In Vitro Assays Are Transforming Nonclinical Toxicology Read the article by Xiaoxia Li here - americanpharmaceuticalreview.com/Vitro-Assays-N… #Toxicology #InVitroTesting #3RsPrinciple #EthicalScience #DrugDevelopment #AnimalWelfare #AlternativeMethods

Revolutionizing inhalation product safety: Dr. @Detlef Ritter et al (2023) at the @Fraunhofer ITEM lead the charge in assessing aerosol risks from commercial nebulizers with innovative in vitro testing. Read our latest blog here: hubs.ly/Q02h-3180 #invitrotesting #expoCube
scireq.com
In Vitro Inhalation Testing: Revolutionizing Inhalation Product Safety
Discover how the expoCube was used in a study to understand the possible adverse acute inhalation effects of aerosols on consumer safety.
📷 So what actually is in vitro testing for cosmetics 📷 #invitrotesting #cosmeticstesting #animalfreetesting #nonanimaltesting #betterscience #theprocessofanimaltestinghasneverbeenscientificallyvalidated @CBUK10 @cbuk22 @ArtCBUK

Emulate is a leading company for #invitrotesting, and this funding, led by investor Northpond Ventures with Perceptive Advisors, will enable researchers to replicate and study human biology, and understand drug response with greater precision and detail than animal testing.


At XCellR8, we don't use any animals or animal-derived components in our lab. #animalfreetesting #invitrotesting #safetytesting

We're still at In Cosmetics Global 2018! At this moment our colleague Irene Zaldívar Notario, Ph.D., MBA is teaching the technical seminar "Microbiome VS Skincare". One more year with great audience success!#ZurkoResearch #ClinicalEvaluation #InVitroTesting

📷 So what actually is in vitro testing for cosmetics 📷 #invitrotesting #cosmeticstesting #animalfreetesting #nonanimaltesting #betterscience #theprocessofanimaltestinghasneverbeenscientificallyvalidated @CBUK10 @cbuk22 @ArtCBUK

Excited to be with our colleagues and peers at BIO International Convention. Who will we see here?#bio2017 #invitrotesting #hepatocytes

Meet Cytes Biotechnologies, SL R&D Director, Natalia Sánchez Romero, at #EUROTOX2019 Today, she is presenting our Poster: P06-101 "Primary human hepatocytes production for pharmacology, toxicology and basic research: four years experience" @EUROTOX_ #InVitroTesting

Seguimos en In Cosmetics Global 2018! En estos momentos nuestra compañera Irene Zaldívar Notario, Ph.D., MBA está impartiendo el seminario técnico "Microbiome VS Skincare". Un año más con gran éxito de audiencia! #ZurkoResearch #ClinicalEvaluation #InVitroTesting

Visit LifeNet Health LifeSciences expert scientists at #2021SOT. They are eager to share exciting developments around our expanding portfolio of high-quality, human-based research solutions. #invitrotesting #human3Dmodels #safetyassessment bit.ly/3bDiRgq

Visit LifeNet Health LifeSciences expert scientists at #2021SOT Booth#1322. They are eager to share exciting developments around our expanding portfolio of high-quality, human-based research solutions. #invitrotesting #human3Dmodels #safetyassessment bit.ly/3bDiRgq

One #2021SOT session focused on future animal-free tox testing & use of new alternative methodologies. LNH LifeSciences is developing multilayered & multicellular models to help in addressing this effort. #invitrotesting #human3Dmodels #safetyassessment bit.ly/3bDiRgq

The market for #primarycellculture is expanding in part because primary cell cultures are being used for #invitrotesting and #medicationscreening. Read More: bit.ly/43LwUc3

[Apprenticeship at HelioScreen Cosmetic Science] We are pleased to announce the arrival of our last recruit, Anaïs Tabariès, her mission is to create a biodegradability method to offer you a new test very soon ⚗🧪🧴 Welcome to our team, Anaïs! 💪 #invitrotesting #cosmetic
![centreWENEOS's tweet image. [Apprenticeship at HelioScreen Cosmetic Science]
We are pleased to announce the arrival of our last recruit, Anaïs Tabariès, her mission is to create a biodegradability method to offer you a new test very soon ⚗🧪🧴
Welcome to our team, Anaïs! 💪
#invitrotesting #cosmetic](https://pbs.twimg.com/media/FCnbc6WXsAQty1f.png)
In this paper, the teams from @Poietis and @BASF worked together to refine a 4D bioprinting protocol in which microvalve and laser-assisted printing techniques were used to produce skin equivalent tissue ... Read more here: scintica.com/products/ngb-r… #bioprinting #invitrotesting

[Apprenticeship at HelioScreen Cosmetic Science]☀️🧴 We are pleased to announce the arrival of our new recruit, Célia, who will support the commercial department.☀️ Welcome in our team Célia! ☀️🧴 #invitrotesting #invitro #cosmetic #science #infrared #bluelight #sunprotection
![centreWENEOS's tweet image. [Apprenticeship at HelioScreen Cosmetic Science]☀️🧴
We are pleased to announce the arrival of our new recruit, Célia, who will support the commercial department.☀️
Welcome in our team Célia! ☀️🧴
#invitrotesting #invitro #cosmetic #science #infrared #bluelight #sunprotection](https://pbs.twimg.com/media/FbjidFrWIAEy2c0.jpg)
[Apprenticeship at HelioScreen Cosmetic Science]☀️🧴 We are pleased to announce the arrival of our new recruit, Lisa, who will support the commercial and marketingdepartment.☀️ Welcome in our team Célia! ☀️🧴 #invitrotesting #invitro #cosmetic #science #infrared #sunprotection
![centreWENEOS's tweet image. [Apprenticeship at HelioScreen Cosmetic Science]☀️🧴
We are pleased to announce the arrival of our new recruit, Lisa, who will support the commercial and marketingdepartment.☀️
Welcome in our team Célia! ☀️🧴
#invitrotesting #invitro #cosmetic #science #infrared #sunprotection](https://pbs.twimg.com/media/FbjjnrvXoAIqgVk.jpg)
FREE DOWNLOAD: Three new posters at the recent EUROTOX 2023 meeting are now available for download. Get yourself up to speed on the latest in vitro innovation! Download: ow.ly/cLNu50PPTyX #invitrotesting #betterscience #eurotox

We are attending #EUROTOX2019 held in Helsinki (Finland), from 8th to 11th September. Meet us in our poster presentation (P06-101) or contact us to schedule a meeting! More info: bit.ly/2lD7zB2 @EUROTOX_ #InVitroTesting

Below, Junior Toxicologist Ben Arceneaux goes into detail about new approach methods in Toxicology— specifically, that of in vitro testing for chemical safety. 🧪 Learn More: hubs.la/Q02x-V0b0 - #InVitroTesting #Toxicology #NewApproachMethods #NAMs

Embracing the Future: How In Vitro Assays Are Transforming Nonclinical Toxicology Read the article by Xiaoxia Li here - americanpharmaceuticalreview.com/Vitro-Assays-N… #Toxicology #InVitroTesting #3RsPrinciple #EthicalScience #DrugDevelopment #AnimalWelfare #AlternativeMethods

Something went wrong.
Something went wrong.
United States Trends
- 1. $NVDA 67.5K posts
- 2. Jensen 20.4K posts
- 3. GeForce Season 4,974 posts
- 4. #happybdayTYGA N/A
- 5. Peggy 36.9K posts
- 6. #ใครในกระจกEP5 9,383 posts
- 7. Sumrall 2,072 posts
- 8. Saba 10.8K posts
- 9. Stargate 6,192 posts
- 10. Martha 18.9K posts
- 11. #WWESuperCardNewSeason N/A
- 12. #2Kgiveaway N/A
- 13. Comey 54.8K posts
- 14. Poverty 51.7K posts
- 15. The Fugitive 2,829 posts
- 16. EPS of $1.30 N/A
- 17. NASA 51.1K posts
- 18. Jason Crow 2,450 posts
- 19. Sonic 06 3,579 posts
- 20. Kwame 6,463 posts




























